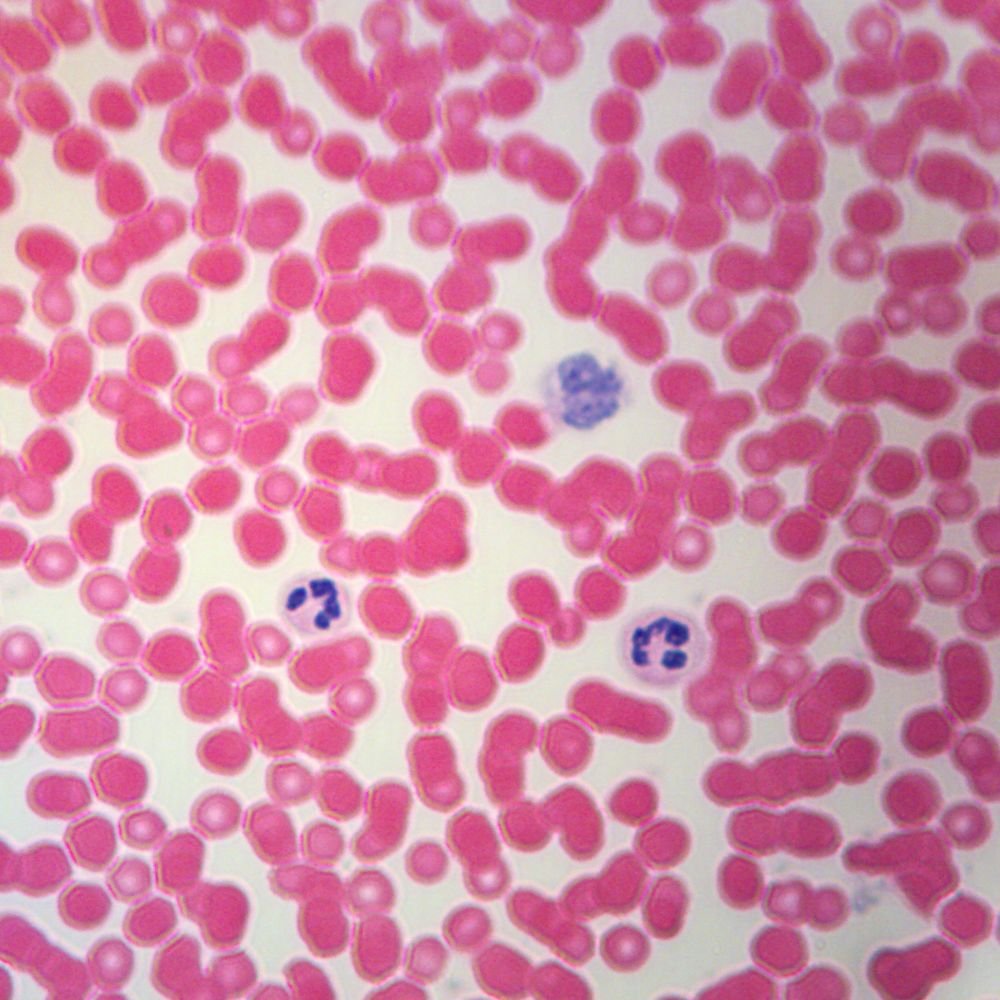

Home ⇨ Human blood cells images
Human Blood Cells Images
Get Human blood cells images For Free - Find your perfect HD wallpaper for your phone, desktop, website or more! - Free download - High-quality wallpapers - Advanced filters for searching. Today i will share Human blood cells images wallpaper. At The Best Wallpaper Place you will find a large assortment of designer and glitter wallpaper. Choose your designer wallpaper online today.

Get Human blood cells images For Android Free